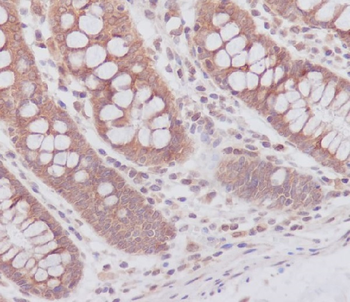
ATG7 Rabbit mAb

You have no items in your shopping cart.
Cart summary
Item 1 of 1
ATG7 Rabbit mAb
Catalog Number: orb1565253
Product Properties
| Catalog Number | orb1565253 |
|---|---|
| Category | Antibodies |
| Description | ATG7 Rabbit mAb |
| Target | ATG7 |
| Clonality | Monoclonal |
| Isotype | IgG |
| Conjugation | Unconjugated |
| Reactivity | Human, Mouse, Rat |
| Form/Appearance | Liquid |
| Concentration | 0.3 mg/ml |
| Buffer/Preservatives | 50mM Tris-Glycine(pH 7.4), 0.15M NaCl, 40%Glycerol, 0.01% sodium azide and 0.05% rAlbumin. |
| Purification | Affinity Purified |
| Immunogen | A synthetic peptide of human Apg7 |
| UniProt ID | O95352 |
| MW | Calculated MW: 78 kDa; Observed MW: 78 kDa |
| Tested applications | WB |
| Dilution range | WB: 1/500-1/1000 |
| Antibody Type | Primary Antibody |
| Clone Number | R09-4E8 |
| Storage | Maintain refrigerated at 2-8°C for up to 2 weeks. For long term storage store at -20°C in small aliquots to prevent freeze-thaw cycles. |
| Alternative names | hAGP7; Ubiquitin-activating enzyme E1-like protein Read more... |
| Research Area | Cell Biology |
| Note | For research use only |
Images

Western blot analysis of Apg7 in K562, rat Brain, C6, 3T3, Hela lysates using ATG7 antibody.
Similar Products
Atg7(Apg7) Rabbit mAb [orb1950954]
ICC, WB
Human, Mouse, Rat
Rabbit
Recombinant
Unconjugated
50 μl, 100 μlATG7 Recombinant Rabbit mAb [orb2326491]
ICC, WB
Human, Mouse, Rat
Rabbit
Recombinant
Unconjugated
100 μl, 50 μl, 25 μlATG7 Recombinant Rabbit mAb [orb2324891]
FC, ICC, IHC, IP, WB
Human
Rabbit
Recombinant
Unconjugated
100 μl, 50 μl, 25 μl
Reviews
ATG7 Rabbit mAb (orb1565253)
Based on 0 reviews
Participating in our Biorbyt product reviews program enables you to support fellow scientists by sharing your firsthand experience with our products.
Login to Submit a Review